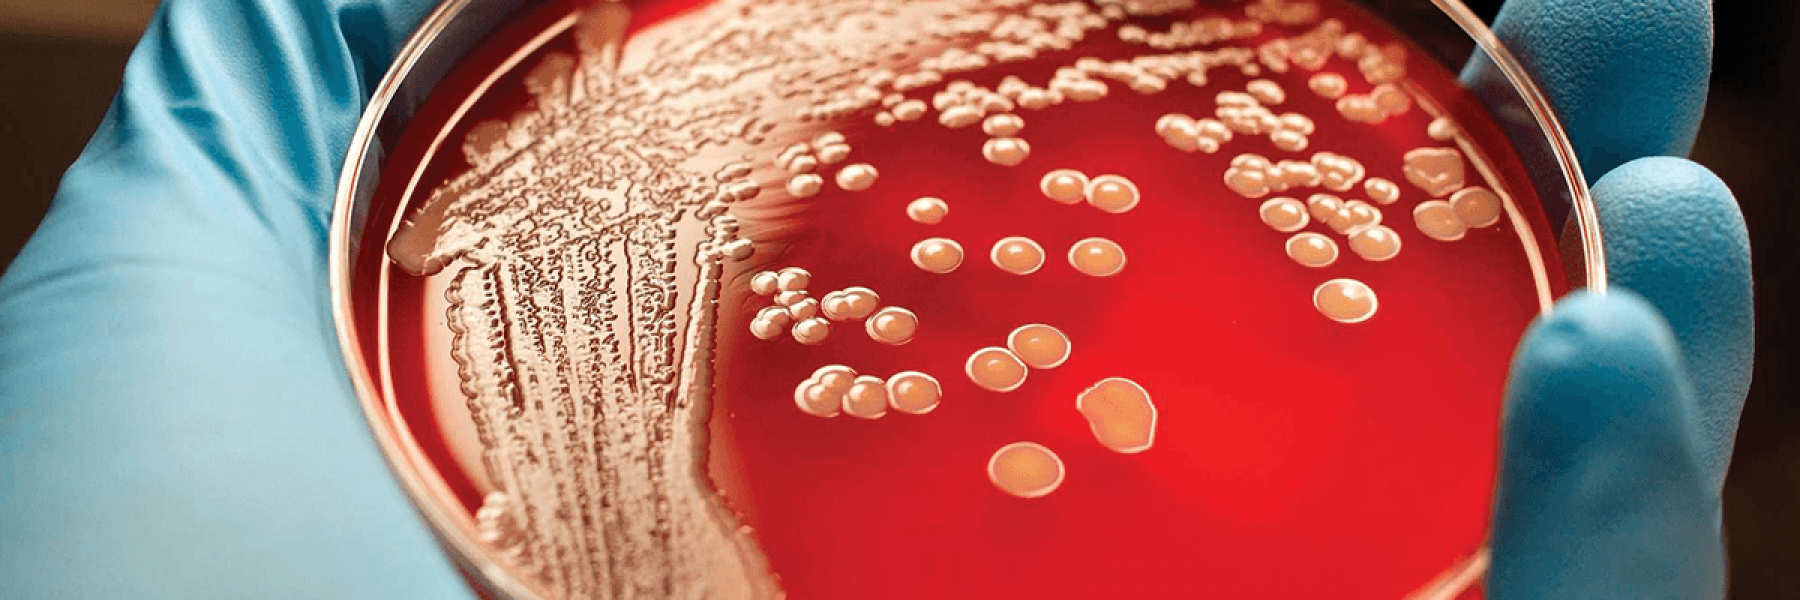
مرض اللوكيميا

يشير اللوكيميا إلى نوع من السرطان يؤثر على خلايا الدم ونخاع العظام، وهو السبب الأكثر شيوعًا للوفيات المرتبطة بالسرطان في الولايات المتحدة الأمريكية.
وقد تبدو التوقعات بشأن اللوكيميا معقدة للتنبؤ بها بسبب الأنواع المختلفة منها، حيث تكون بعض الأنواع بطيئة النمو، بينما ينتشر البعض الآخر بسرعة، ولكل منها أعراض وخيارات علاج مختلفة، لذا تابعي من خلال هذه المقالة للتعرف على كل نوع حتى تتمكني من فهم خيارات العلاج.
أنواع اللوكيميا
1- ابيضاض الدم النقوي المزمن
يبدأ سرطان الدم النخاعي المزمن في نخاع العظم، مما ينتج عنه عدد كبير بشكل غير طبيعي من خلايا الدم البيضاء غير الصحية المعروفة باسم الخلايا الحبيبية.
ويعرف أيضًا باسم سرطان الدم الحُبيبي المزمن أو النخاعي، ويعتقد أنه يعزى جزئيًا إلى طفرات جينية تسمى كروموسومات فيلادلفيا، ويعتبر هذا النوع من اللوكيميا هو الأكثر شيوعًا عند البالغين ونادر الحدوث عند الأطفال.
ومع تقدم سرطان الدم النخاعي المزمن، تستحوذ الخلايا الحبيبية على نخاع العظام والدم بحيث لا يوجد مكان لخلايا الدم الحمراء أو الصفائح الدموية أو خلايا الدم البيضاء السليمة.
وتشمل بعض الأعراض الأولية لهذا النوع:
- تعب مفرط
- فقدان الوزن غير المبرر
- تعرق ليلي
- حمى
- ألم أسفل القفص الصدري الأيسر
- العلاجات
أحد المجالات الواعدة لعلاج سرطان الدم النخاعي المزمن يتضمن علاجات موجهة تعالج الطفرات غير الطبيعية من كروموسوم فيلادلفيا، حيث وجد الباحثون أن العلاجات المستهدفة يمكن أن تساعد الأشخاص المصابين بسرطان الدم النخاعي على البقاء بالقرب من متوسط العمر المتوقع أو الطبيعي.
2- ابيضاض الدم الليمفاوي المزمن
يحدث هذا النوع في نخاع العظام أيضًا، مما يؤدي إلى إنتاج عدد كبير جدًا من الخلايا الليمفاوية، وهو نوع آخر من خلايا الدم البيضاء، ومثل النوع السابق الذي ذكرناه، يحدث ابيضاض الدم الليمفاوي المزمن عند البالغين وشائع جدًا بينهم، بينما نادر الحدوث عند الأطفال.
ومن أعراض هذا النوع:
- تورم الغدد الليمفاوية
- تعب مفرط
- سهولة حدوث كدمات أو نزيف
العلاجات
تستخدم العلاجات المستهدفة أيضًا في حالات ابيضاض الدم الليمفاوي المزمن المبكر، حيث أظهرت الأبحاث أن العلاجات المركبة قد تكون أكثر فعالية مقارنة باستخدام علاج موجّه واحد في وقت واحد، وقد يشمل العلاج استخدام العلاج بالخلايا التائية.

3- ابيضاض الدم النخاعي الحاد
يحدث ابيضاض الدم النخاعي الحاد عندما يكون هناك خلايا دم بيضاء غير طبيعية في جسمك تسمى خلايا الدم النخاعية، ويسمى هذا النوع من السرطان أيضًا باللوكيميا النقوية وهو الشكل الأكثر شيوعًا لسرطان الدم الحاد وهو الأكثر خطورة لأنه يتطور بسرعة.
العلاجات
يعالج سرطان الدم النخاعي الحاد بالعلاج الكيميائي والعلاج الإشعاعي، وتعد العلاجات المستهدفة المختلفة جديدة نسبيًا في علاج سرطان الدم النخاعي المزمن، وحتى الآن لا يزال هناك المزيد من الأبحاث للحصول على تركيبات مختلفة.
4- ابيضاض الدم الليمفاوي الحاد
وهو سرطان مسؤول عن تكوين عدد كبير جدًا من الخلايا الليمفاوية، وهو سريع التطور خاصة إذا ترك دون علاج، وهو أكثر انتشارًا عند الأطفال.
العلاجات
يستخدم العلاج بالخلايا التائية حاليًا في الأطفال والشباب المصابين بابيضاض الدم الليمفاوي الحاد، ولا زال البحث جاريًا حتى الآن للتمكن من استخدام العلاج ذاته ولكن لكبار السن المصابين بهذا النوع من السرطان.